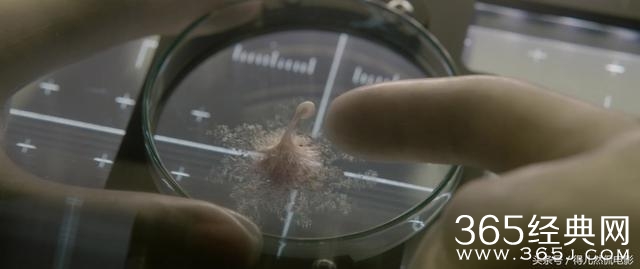

本文由“得儿然侃电影”原创,图片来源于网络(侵删),转载请注明出处“头条号:得儿然侃电影”

异星觉醒
警告:本片包含大量血腥,触手,阴暗情绪等相关元素,胆小勿看!!
警告:本片包含大量血腥,触手,阴暗情绪等相关元素,胆小勿看!!火影忍者剧情介绍
警告:本片包含大量血腥,触手,阴暗情绪等相关元素,胆小勿看!!火影忍者剧情介绍
各位观众老爷大家好,我是你们的老司机-得儿然。今天给大家带来的影片,是由美版吴彦祖-杰克.吉伦哈尔主演的《异星觉醒》。虽然得儿然自诩爱好反合家欢类型影片,《迷雾》《僵尸》《电锯惊魂》《恐怖游轮》也是看了又看,这次在影院真实感受了一把大荧幕的反合家欢影片(没错!这种负能量的影片,电影院一般上映的比较少,得儿然以前看的都是在线看的),感觉棒棒哒!晚上都不敢盖薄被子,怕做噩梦!因此,各位观众如果在未了解影片内容就跑影院的,小心受到万点伤害!

杰克.吉伦哈尔颜值担当
《异星觉醒》的影片模版选择的是30年前的太空怪兽片之祖《异形》。《异形》是由标准的恐怖片转型而来的,血腥,恶心,美女,裸露,恐惧各种临界点的情绪接踵而来。相比远古的魔王《异形》,《异形觉醒》则显得理性稚嫩的不像商业电影了。没有用到美女和帅哥的情感,反而在真田广之这样的大叔身上下功夫,真是奇怪。

《异形》的美女诱惑

《异星觉醒》的美女诱惑
抱怨归抱怨,抛开整部影片的所有硬科幻迷们无法理解的bug,其实这部影片还是非常有张力的!不过,今天不是要讲这些,要讲的是那些坑死人的猪队友!
首先,飞船接到了一个火星报废回来的卫星。由残疾的黑人科学家,负责培养在火星采集到的一个单细胞。(记住这个黑人)

警察蜀黍!就是他!
这个黑人还是很厉害的,噼里啪啦的就把单细胞生物弄活,大概是这样事儿的。
火星生物初长成
又过了几天,长得还挺萌,有点像《银河护卫队》的小格鲁特。

火星生物

格鲁特
可是意外突然发生了,由于培养装置的大气环境发生改变,火星生物-达尔文,突然休眠了。吓坏了的黑人开始用电棒,戳这个火星生物。这……谁拿硬邦邦的小棒棒戳你你也不能忍吧?尤其还是在你睡觉的时候!火星生物也有起床气,一下子把黑人的手撅折了,并逃出了培养器,进入房间,吃掉了小白鼠。

被电棒戳的达尔文
由此,我们可以发现,达尔文属于高等生物,进化迅速,有智慧,同时具有攻击性。黑人遇袭时都怂的不行的队友,这时候冲来了一个!没错!就只有一个!这好比,你明明可以两个人来gank对手,却非要一个一个送。

1号选手
1号选手,救出黑人,用喷火器杀敌失败,扑街!

2号选手
2号选手是舰长,除了1号选手外,舱外作业最好。由于达尔文吃掉了通讯系统的冷却剂,2号选手必须在舱外修理,2号选手遇袭。由于太空服的损坏,导致冷却剂泄漏到衣服内部,2号选手有无数次机会,抱着达尔文,消失在浩瀚的宇宙,但是她没有,最后在舱门口断气而亡。

3号选手
3号选手是黑人,黑人是传说中的演员,当所有幸存成员决定排出其余房间空气,将达尔文置于宇宙真空环境中时。黑人用自己的裤管带着达尔文偷溜进屋?还给它自己的右腿吃?还屏住呼吸不说话?
3号选手,死得其所!

4号选手
4号选手的老婆刚生完孩子,所以他的求生意识很强。3号选手惨死后,5,6号选手1个房间,4号选手和达尔文一个房间。通讯不畅通,让4号选手凭自己的意志行动,不仅没有自救,反而把达尔文带到了5,6号选手的房间。
4号选手,扑街。

5号选手
5号选手和6号选手处于,如果什么都不做,达尔文就会到地球,危及地球人民,而且他们两个也必死无疑。如果他们采取牺牲一个的战略,战略成功,那么还有一个可以平安回地球,达尔文也不会到地球。
5号选手和6号选手非常开心的执行计划。之后就是结局,小编就不剧透了……想看就去电影院,前提,你能接受触手,血腥等重口味画面。

落向地球的救生舱究竟装的是啥?
总之,《异星觉醒》的编剧BUG非常多,为什么外星生物在宇宙环境中能长达5分钟不死?为什么用仅剩的燃料就能让救生舱达到逃逸速度?(牛顿的棺材板都快按不住了!高中生都知道的物理必考知识点啊!)为什么整艘飞船没有自毁程序?其他………………拿什么拯救你?我的猪队友?
忽略掉这些问题,《异星觉醒》算是部不错的恐怖片呢~
影片评分:6分/10分
推荐人群:
能快速摆脱阴暗情绪的情商帝
触手控
异形同好会

头条影评团
(喜欢这篇文章记得转发给你的好友,长得好看的都会订阅“得儿然侃电影”)
本期留言板主题:面对未知能力的敌人,你是选择与其同归于尽保队友,还是拉队友与之共同战斗?
娱乐圈中被包养的女星数不胜数,包养男人的女星也数不胜数,但是很多女星被包养后还死 ...
讲到女性做爱至高潮算得上是一件很神秘的事情,因为男女之间的区别,男性在高潮时伴有 ...
近日,一美国19岁女孩在图书馆里面不管不顾公众场所,公然自慰事件引起了网友们的关注 ...
昨天,院长写了一篇关于电影《大只佬》的原版解析。这部当年囊括23届金像奖多个奖项的 ...
据韩国媒体日刊体育报道,《RunningMan》改版,金钟国被裁,宋智孝也被节目组抛弃。宋 ...